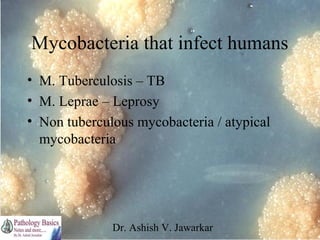
Mycobacteria that infect humans
• M. Tuberculosis – TB
• M. Leprae – Leprosy
• Non tuberculous mycobacteria / atypical
mycobacteria

Dr. Ashish V. Jawarkar
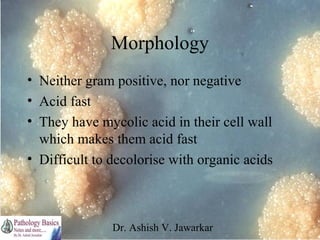
Morphology
• Neither gram positive, nor negative
• Acid fast
• They have mycolic acid in their cell wall
which makes them acid fast
• Difficult to decolorise with organic acids

Dr. Ashish V. Jawarkar
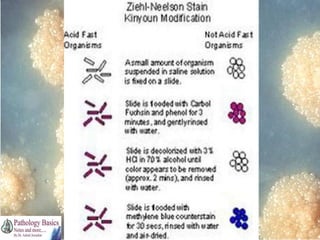
Dr. Ashish V. Jawarkar
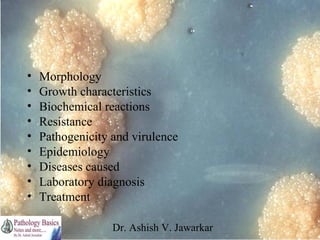
•
•
•
•
•
•
•
•
•

Morphology
Growth characteristics
Biochemical reactions
Resistance
Pathogenicity and virulence
Epidemiology
Diseases caused
Laboratory diagnosis
Treatment
Dr. Ashish V. Jawarkar
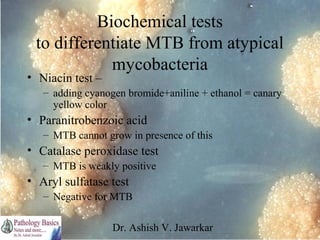
Biochemical tests
to differentiate MTB from atypical
mycobacteria

• Niacin test –

– adding cyanogen bromide+aniline + ethanol = canary
yellow color

• Paranitrobenzoic acid
– MTB cannot grow in presence of this

• Catalase peroxidase test
– MTB is weakly positive

• Aryl sulfatase test
– Negative for MTB
Dr. Ashish V. Jawarkar
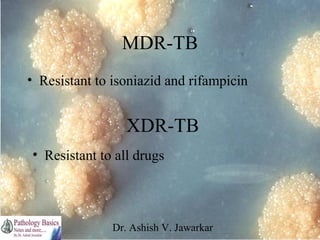
MDR-TB
• Resistant to isoniazid and rifampicin

XDR-TB
• Resistant to all drugs

Dr. Ashish V. Jawarkar
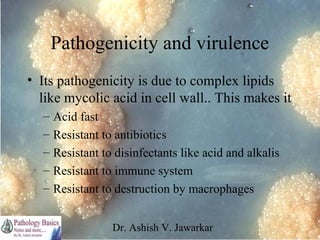
Pathogenicity and virulence
• Its pathogenicity is due to complex lipids
like mycolic acid in cell wall.. This makes it
–
–
–
–
–

Acid fast
Resistant to antibiotics
Resistant to disinfectants like acid and alkalis
Resistant to immune system
Resistant to destruction by macrophages
Dr. Ashish V. Jawarkar
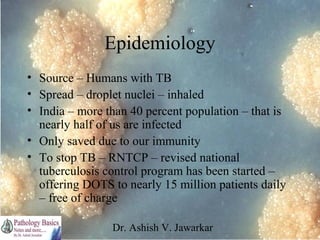
Epidemiology
• Source – Humans with TB
• Spread – droplet nuclei – inhaled
• India – more than 40 percent population – that is
nearly half of us are infected
• Only saved due to our immunity
• To stop TB – RNTCP – revised national
tuberculosis control program has been started –
offering DOTS to nearly 15 million patients daily
– free of charge
Dr. Ashish V. Jawarkar
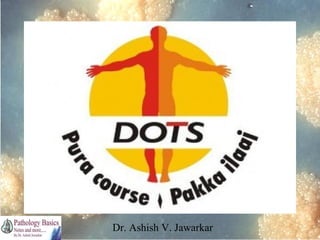
Dr. Ashish V. Jawarkar
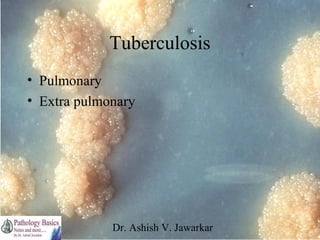
Tuberculosis
• Pulmonary
• Extra pulmonary

Dr. Ashish V. Jawarkar
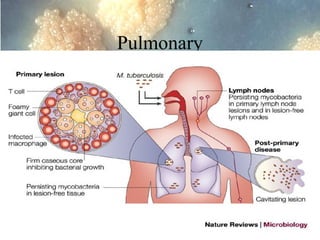
Pulmonary

Dr. Ashish V. Jawarkar
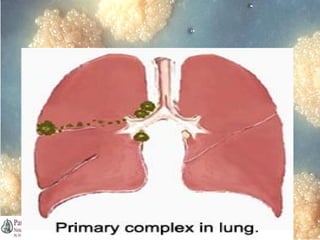
Dr. Ashish V. Jawarkar
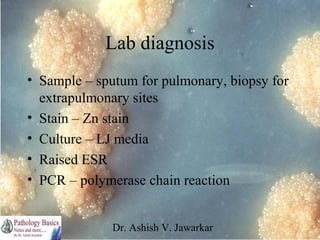
Lab diagnosis
• Sample – sputum for pulmonary, biopsy for
extrapulmonary sites
• Stain – Zn stain
• Culture – LJ media
• Raised ESR
• PCR – polymerase chain reaction
Dr. Ashish V. Jawarkar
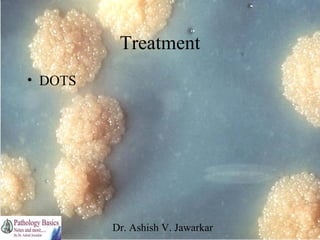
Treatment
• DOTS

Dr. Ashish V. Jawarkar
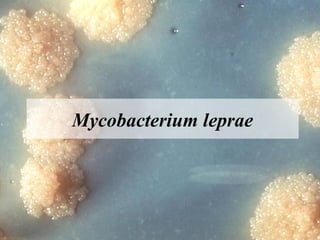
Mycobacterium leprae

Dr. Ashish V. Jawarkar
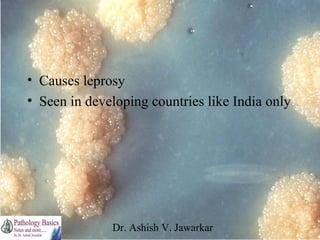
• Causes leprosy
• Seen in developing countries like India only

Dr. Ashish V. Jawarkar
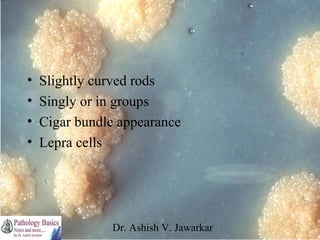
•
•
•
•

Slightly curved rods
Singly or in groups
Cigar bundle appearance
Lepra cells

Dr. Ashish V. Jawarkar
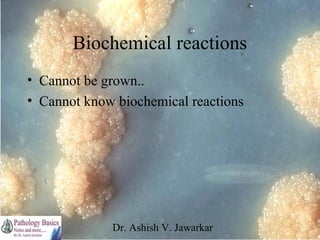
Biochemical reactions
• Cannot be grown..
• Cannot know biochemical reactions

Dr. Ashish V. Jawarkar
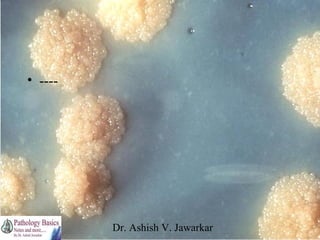
• ----

Dr. Ashish V. Jawarkar
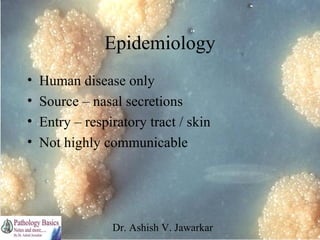
Epidemiology
•
•
•
•

Human disease only
Source – nasal secretions
Entry – respiratory tract / skin
Not highly communicable

Dr. Ashish V. Jawarkar
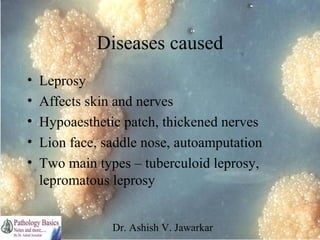
Diseases caused
•
•
•
•
•

Leprosy
Affects skin and nerves
Hypoaesthetic patch, thickened nerves
Lion face, saddle nose, autoamputation
Two main types – tuberculoid leprosy,
lepromatous leprosy
Dr. Ashish V. Jawarkar
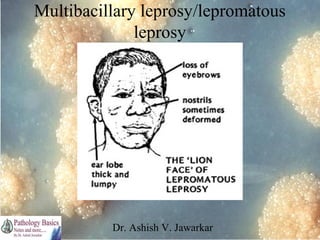
Multibacillary leprosy/lepromatous
leprosy

Dr. Ashish V. Jawarkar
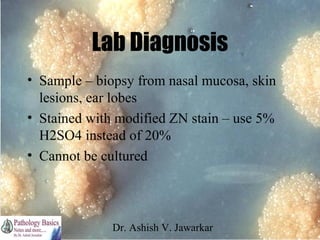
Lab Diagnosis
• Sample – biopsy from nasal mucosa, skin
lesions, ear lobes
• Stained with modified ZN stain – use 5%
H2SO4 instead of 20%
• Cannot be cultured

Dr. Ashish V. Jawarkar
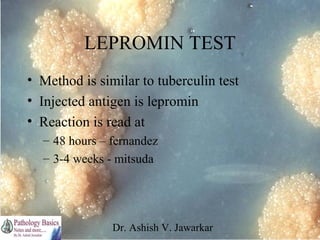
LEPROMIN TEST
• Method is similar to tuberculin test
• Injected antigen is lepromin
• Reaction is read at
– 48 hours – fernandez
– 3-4 weeks - mitsuda

Dr. Ashish V. Jawarkar
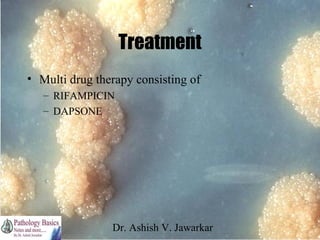
Treatment
• Multi drug therapy consisting of
– RIFAMPICIN
– DAPSONE

Dr. Ashish V. Jawarkar
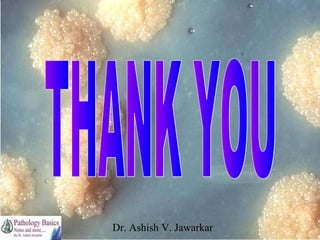
Dr. Ashish V. Jawarkar

The document covers the characteristics, pathogenicity, epidemiology, laboratory diagnosis, and treatment of mycobacterium, focusing on Mycobacterium tuberculosis and Mycobacterium leprae. It explains the morphology of these bacteria, their growth conditions, biochemical reactions for differentiation, and treatment options, including multi-drug therapies. Additionally, it highlights public health initiatives like the Revised National Tuberculosis Control Program in India to combat tuberculosis.